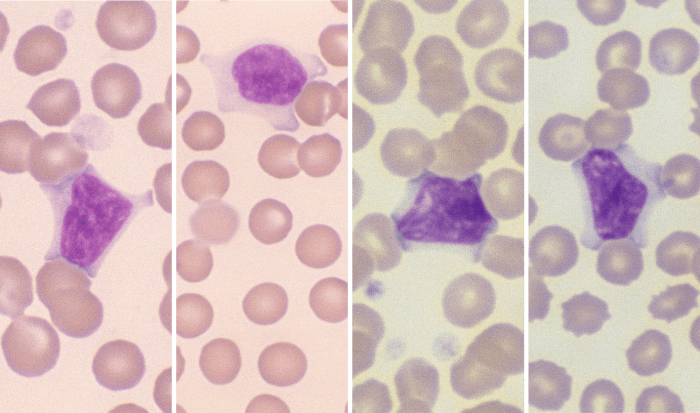
Lymphocytes 1-4 (Canine 1 -4) ARROWS
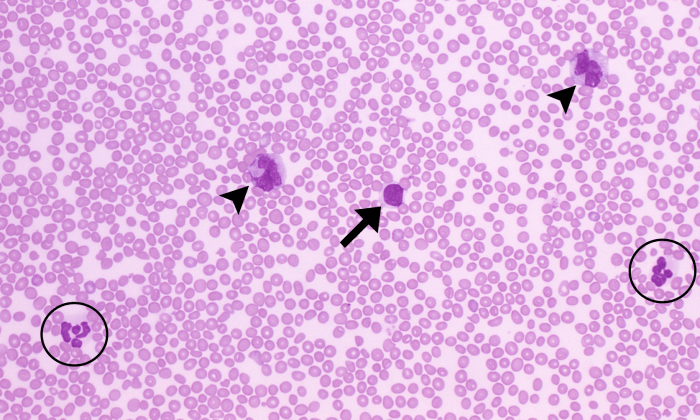
Lymphocytes 15 (Goat 1) ARROWS

Mature Lymphocytes

Morphology: small round leukocytes with round or indented nuclei, dark clumped chromatin, and small amounts of light blue cytoplasm. Cattle have small lymphocytes (as described), as well as large lymphocytes with dark areas in the nucleus (chromocenters) and abundant pale blue cytoplasm. T-lymphocytes and B-lymphocytes usually cannot be differentiated on routine blood smears, except for plasma cells and granular lymphocytes (which are either cytotoxic T-cells or natural killer cells).
Look alike: nucleated red blood cells, monocytes
Clinical relevance: small numbers of lymphocytes are seen in the blood of healthy animals (lymphocytes are the predominant leukocyte in cattle). Lymphocytosis (↑ lymphocytes in peripheral blood) may be associated with chronic antigenic stimulation (bacterial, viral, rickettsial infections or vaccination), extreme excitement or stress (epinephrine release), or lymphocytic leukemias (lymphocyte morphology may be abnormal).